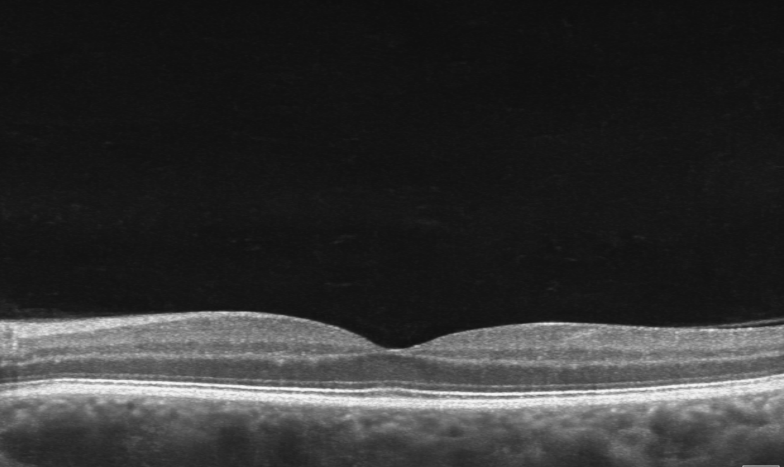
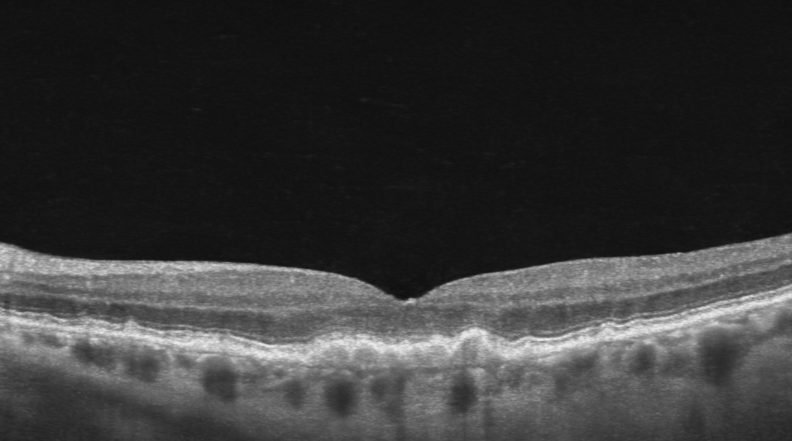

What to Know About Macular Degeneration
Macular degeneration (MD), more accurately known as age-related macular degeneration (AMD), is a common eye condition that affects the central part of your vision.
The macula is the part of the retina responsible for seeing fine detail—things like reading, recognising faces, and driving. Over time, these cells can gradually wear down, leading to patchy or distorted vision.
Just like we notice grey hair or wrinkles as we get older, changes are also happening inside the eye—but you can’t see these in the mirror. Fortunately, your optometrist can detect early signs using retinal photos and OCT scans during a regular eye exam.
What is Macular Degeneration—and Who Gets It?
Macular degeneration is a degenerative condition that causes distortion or loss of central vision.
Put simply—if we live long enough, many of us will develop some level of macular degeneration. It generally develops slowly over many years, and the early signs are seen in a routine eye examination. The goal is to slow down, not speed up the aging process.
Some notice changes in their 60s
Most people in their 70s have early signs, that don’t yet affect their vision
Others maintain good macula health into their 80s
Early Signs of Macular Degeneration
Macular degeneration rarely appears “suddenly”—there are usually early warning signs.
These warning signs are best detected during a comprehensive eye exam, including:
Vision testing
Retinal imaging with photos
OCT scanning (to see deeper retinal layers)
Retinal photo Normal Macula
What your optometrist sees:
The earliest signs are small pale deposits called drusen. These are like “cellular waste” that builds up in the retina over time.
As drusen increase:
The retina becomes less healthy
The macula may start to distort
Vision can gradually be affected
What you might notice:
Straight lines looking wavy or distorted
Difficulty reading full words (seeing parts instead)
Patchy or blurred central vision
You may be given a simple grid (Amsler grid) to monitor changes at home.
Retinal photo of drusen in Macular Degeneration
OCT image of normal macula
What Can You Do to Protect Your Vision?
1. Have Regular Eye Exams
Regular eye examinations are the most important step.
At Visique CapitalEyes Optometrists, we:
Show you images of your retina
Explain any early changes
Recommend how often you should return, based on the rate of change and severity of the signs.
For some people, every 2 years is enough. Others may need more frequent monitoring with OCT scans.
Early detection means early treatment if needed—which can save vision.
2. Don’t Fast-Track the Ageing Process
Lifestyle plays a big role in macular health.
Protect your eyes by:
Not smoking
Managing blood pressure and cholesterol
Wearing sunglasses for UV protection
Eating a diet rich in leafy greens and colourful vegetables
For some people a dietary supplement with vitamins and anti-oxidants may help reduce risk of further progression - our optometrists at CapitalEyes can advise on this
Managing Macular Degeneration
If macular degeneration progresses, the key concern is whether fluid develops in the retina.
If this happens:
You’ll need urgent referral to an ophthalmologist
Treatment may involve injections to stabilise vision
Early treatment gives the best outcomes
Regular monitoring (sometimes every 3–6 months) ensures nothing is missed.
OCT image of drusen in Macular Degeneration
Practical Tips for Living with Macular Degeneration
Small changes can make a big difference:
💡 Improve lighting
Good lighting—very close to what you’re reading—can dramatically improve vision.
🔍 Make things bigger
Increase text size on devices
Use larger screens
Consider magnifiers or glasses focussed closer
📱 Use technology
Modern devices can help with:
Zoom in easily
Read text aloud
Enhance contrast
Keep up with technology, it is your friend. And yes—grandkids are usually great tech support!
Knowing that as we all live longer than ever, we will all likely retire from driving at some stage. Having a plan around this, helps you and others manage if your vision changes.
What Our Karori Optometrists Want You to Know
Macular degeneration is usually slow and manageable
It is not truly sudden, even if it feels that way
Regular checks help detect risk early, and assess rates of change
With your optometrist taking the time to explain, it helps you and your family understand your vision and possible changes, making an MD diagnosis a more manageable health condition
Sudden changes should always be assessed urgently
We see macular degeneration every day in Karori and help patients manage it with personalised advice.
With the right care, knowledge, and support, macular degeneration becomes far less frightening—and far more manageable.